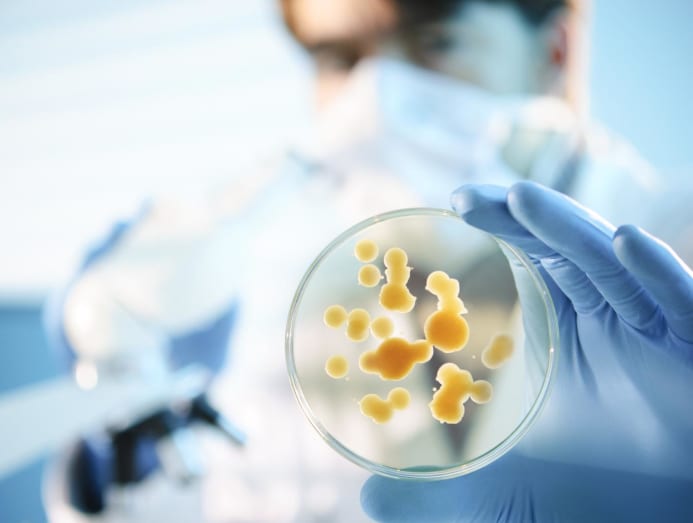

How do you know if that red, itchy rash is a fungal infection or not?
Our hot and humid climate, along with tight clothes and walking barefooted on dubious floors, creates the perfect breeding ground for fungi, yeast and mould.

(Photo: iStock/RyanKing999)

This audio is generated by an AI tool.
It may seem farfetched to associate The Last Of Us with real life, but fungal infections (maybe not the kind that turns humans into cordyceps zombies) have been with us for as long as we exist. Ringworm, athlete’s foot, white spots, yeast infections… these are the results of fungal, yeast or mould spores that literally take root in our bodies.
“Fungal infections are common and are ranked in the top 10 common skin conditions seen at National Skin Centre,” said Adjunct Associate Professor Pan Jiun Yit, a senior consultant and the chief of the centre's Cutaneous Infection Unit.
Dermatologists in private practice also see cases regularly. “A common fungal skin condition is tinea versicolour, or the so-called ‘white spots’ on the body,” said Dr Joyce Lim from SOG Health. And no, it is not caused by neglecting to clean sweat off after physical activities, she said.
Aesthetics doctors such as Dr Melinda Goh from S Aesthetics Clinic have treated fungal cases as well. “Our warm, humid climate promote fungal growth on skin and nails, increasing the risk of infections like athlete’s foot and ringworm due to heightened sweating and moisture.”
If you’ve had or are still grappling with a fungal infection, you’d know it takes a long time to go away. Why is that and how do you recognise an infection when you see one? Here’s what the experts say.

WHAT ARE THE COMMON FUNGAL INFECTIONS?
Dermatophytes, a group of filamentous fungi, are the most common fungi that infects the skin, nails and scalp, said Dr Lim.
Another group that can take over our health is candida, a yeast-like fungus that lives in small quantities on the skin, and mucous membranes such as the mouth and vagina. “The common strain is called candida albicans,” said Dr Lim. When they proliferate, they can lead to thrush, vaginal infection and diaper rash.
Dr Goh added moulds, which can hit the lungs and sinuses, to the list. “They can infect the skin but are more commonly linked to respiratory problems, especially in those with weakened immunity.”
WHAT DO FUNGAL INFECTIONS LOOK LIKE?
According to Dr Lim, a skin fungal infection can cause a rash “that is often circular with active borders and a central clearing” or what is commonly known as ringworm. “They can also cause a rash that looks scaly with tiny bumps, or they can present as white or brown spots.”
Meanwhile, nail infections can result in nail discolourations (yellow, black or brown), a thickened nail plate and often, subungual debris, which refers to the thickening of the nail bed with fungal tissue, explained Dr Lim. “There is also a condition called white onychomycosis, where the fungus is on the nail plate, giving the nail surface a white colour.”

Nail fungal infections “can sometimes occur alongside bacterial infections, which may cause the nail to turn green due to bacterial breakdown products”, she added.
On the scalp, “fungal infections can cause a scaly rash that may progress to pus-filled bumps”, said Dr Lim. “If the infection affects the hairs, it may result in patchy hair loss with scarring. Rarely, big pus-filled nodules called kerion may occur.”
Yeast infections or candida, on the other hand, look different. The affected skin often presents with a red area and red papules outside the area. “Candida is often seen in the groin and under breast folds,” said Dr Lim. “Candida may also be seen on the oral mucosa as white patches.”
If you’re exposed to wet work or frequent hand washing, you may have swollen and painful nail folds called paronychia. “These are often secondarily infected with yeast or fungi,” said Dr Lim.
HOW DO WE GET INFECTED?
“For an infection to occur, the spores must enter the skin, hair or nails from contaminated surfaces in public areas such as swimming pools, gyms, changing rooms, or from shared personal items like towels or footwear,” said Dr Lim. “Close contact with an infected person may also spread the infection.”
“Less often, the fungi within our body may overgrow, leading to an infection,” she said, referring to individuals with reduced immunity. Taking certain medications such as antibiotics may eliminate the good bacteria and microorganisms in the body and cause the fungi to overgrow, said Dr Lim. “Certain medical conditions such as uncontrolled diabetes can also make a person prone to fungal infections.”
WHY DO FUNGAL INFECTIONS TAKE SO LONG TO TREAT?
Fungal nail infections, for instance, can last many years mainly because of the fungi’s ability to hide in hard-to-reach areas and develop resistance to treatments, said Dr Goh.
And symptoms don’t emerge immediately either. “The incubation period for fungal infections can vary depending on the type of fungi and the area affected,” said Dr Lim.
“Generally, it takes between several days and weeks for fungi to grow and become noticeable on the skin or nails. Some infections, like athlete's foot, can develop within a week, while nail infections may take several weeks to become apparent,” she said.
Dr Goh added that “in some cases, the fungi may remain dormant before causing symptoms, especially in immunocompromised individuals”. “Factors such as skin moisture, temperature and immune response play a role in how quickly an infection establishes itself.”
Not only that, getting infected again is common, said Adj Assoc Prof Pan. “There is a chance of reinfection from fungal spores left in the environment, or from person-to-person contact”, so it may seem as if your toenail infection, for example, is taking forever to heal.

CAN FUNGAL INFECTIONS BECOME DANGEROUS?
Only when the infection “involve the bloodstream and internal organs in patients with a weak immune system”, said Adj Assoc Prof Pan. “They usually involve the lungs via inhalation, or the bloodstream via intravenous catheters and devices.” Patients at risk are debilitated or on chemotherapy, he said.
“If there is a fungal infection deep in the skin,” said Dr Lim, these infections “may last a long time and are often resistant to treatment”.
Medication may prove fruitless, too, in cases that involve the nose. Sometimes, a mass known as a fungal ball can develop in the sinuses after you’ve inadvertently inhaled fungal spores. Medications cannot treat it, but a doctor can surgically remove it, said Dr Lim.
“Rarely, fungal balls may be seen in the systemic organs but when they do present in the systemic organs, they become dangerous.”

WHAT ARE THE TREATMENTS AVAILABLE?
There are two routes: Topical (creams, powders and lotions) and oral treatments, said Adj Assoc Prof Pan. “Oral treatments can be prescribed for weeks to months, depending on the severity and site of infection.”
It is important to comply with the prescribed medications, said Dr Goh, to ensure effectiveness and prevent recurrence. “Regular follow-ups with a healthcare provider are recommended for proper management,” she said.
In the meantime, “avoid sharing napkins, towels, combs and hairbrushes; avoid walking around barefoot on wet bathroom floors and common showers; and don’t wear damp footwear or very thick occlusive socks”, said Adj Assoc Prof Pan.






